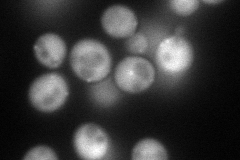
YKL128C
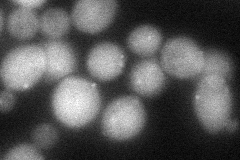
YKL128C
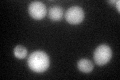
YKL128C
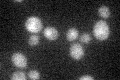
YKL128C

View description
Putative phosphomutase, contains a region homologous to the active site of phosphomutases; overexpression suppresses the histidine auxotrophy of an ade3 ade16 ade17 triple mutant and the temperature sensitivity of a tps2 mutant
Localization:
Intensity:
Fold change:
Significance:
-
C’ GFP library in SD

cytosol43.17 -
N' NOP1pr-GFP in SD
cytosol,punctate110.51 -
N' TEF2pr-mCherry in SD

cytosol,punctate150.082 -
N' NATIVEpr-GFP in SD

punctate44.6967 -
N' TEF2pr-VC and Cyto-VN in SD
cytosol,punctate58.4649 -
C’ GFP library in SD+DTT
cytosol49.431.14No -
C’ GFP library in SD+H2O2

cytosol48.91.13No -
C’ GFP library in Starvation Media
cytosol33.320.77No -
C’ GFP library on the background of Pup2-DaMP

cytosol -
C’ GFP library on the background of CCT mutant

cytosol39.6510.918334No
